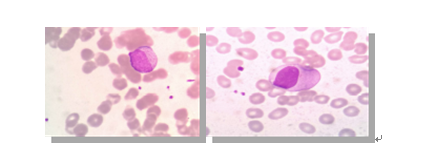

在日常工作时,血常规是许多疾病检查的“第一站”,当遇见血常规检查白细胞减少时,你想到了什么?
白细胞减少原因很多,比如某些传染病包括病毒感染;某些血液病包括再生障碍性贫血、粒细胞缺乏症、骨髓增生异常综合症、少部分急性白血病;化学药品及放射损害等。下面,与大家分享在低白细胞中发现的一例白血病病例。
患者王某,男,45岁,平素健康状况一般,无肝炎、无结核等传染病,无高血压、无糖尿病、无冠心病史,否认地方病、精神病史、职业病史,否认外伤史、输血、中毒史;2020年7月因牙龈出血来我院就诊,血常规检查,白细胞数目:0.98×109/L,中性粒细胞百分比:27.6%,淋巴细胞百分比:62.2%,单核细胞百分比:9.2%,红细胞数目:3.32×1012/L,血红蛋白:103g/L,血小板计数:254×109/L。
标本采集无凝血、无溶血,保证实验前质量。使用检测仪器为希森美康全血细胞分析仪进行检测,室间质控在控,当日室内质控均在控。该标本在血球计数仪器检测出现报警信息,检测的数值触犯了复片规则,从手工推片,到瑞氏染色,到显微镜下阅片,仔细辨认血细胞形态。用油镜在涂片厚薄适中处浏览血片。外周血细胞形态中发现:原始细胞数量占1%,幼稚粒细胞占2%,原始细胞形态:胞体中等,不规则;胞核类圆形,略偏位;核染色质细致;核仁1个。胞质中等,有少许细小颗粒。如下图:
在发检验报告单时特意备注:手工分类可见原始细胞数量占1%,幼稚粒细胞占2%,请到血液科做骨髓穿刺涂片细胞学检查及流式细胞分析等相关检查进一步明确诊断。
骨髓涂片及检查结果如下:

注:黑色箭头为奥尔小体
超敏C反应蛋白:93.84mg/L(参考区间0-5)
结合临床表现及检查综合分型结果,临床最终诊断
1.骨髓增生异常综合征:
该病的外周血中有原始和幼稚细胞,全血细胞减少和染色体异常,容易与白血病相混淆。但骨髓中原始细胞小于20%。该患者骨髓原始髓系细胞占22%,故可鉴别。
2.继发性白细胞较少症:
指继发于某些疾病,或者因某些原因引起的白细胞较少症。常见的继发因素有:病毒感染,物理和化学因素,接触放射线,抗肿瘤药物等。
3.再生障碍性贫血:
表现为发热,贫血,出血三大症状。一般贫血较重,白细胞计数减低,分类淋巴细胞比例明显增高,网织红细胞百分数减低。骨髓增生减低,粒,红系及巨核细胞明显较少,淋巴细胞及非造血细胞明显增高。骨髓活检显示造血组织均匀减少。
白血病是一类造血干祖细胞的恶性克隆性疾病,根据白血病的分化成熟程度和自然病程,将白血病分为急性和慢性两大类。根据患者临床表现、血象、骨髓象可以诊断白血病。
血常规是最基础的检查项目,血常规检查审核报告要注意五个要素:
1.数值2.散点图3.直方图4.报警信息5.临床信息。同时重视复检阅片,因为它对临床疾病筛查、诊断、疗效观察、预后判断有重要的临床意义。
血常规检查对血液疾病的早期诊断尤为重要,特别当遇到低白细胞时,特别要重视。白细胞数量低时,可以多推几张片子,认真复检阅片,只要发现原始细胞,即使只有一个,也要高度重视,及时报告临床并沟通,提出建议下一步需进行的检查或采取的措施,避免漏诊及误诊。这对白血病的早发现,早诊断,早治疗起着举足轻重的作用!